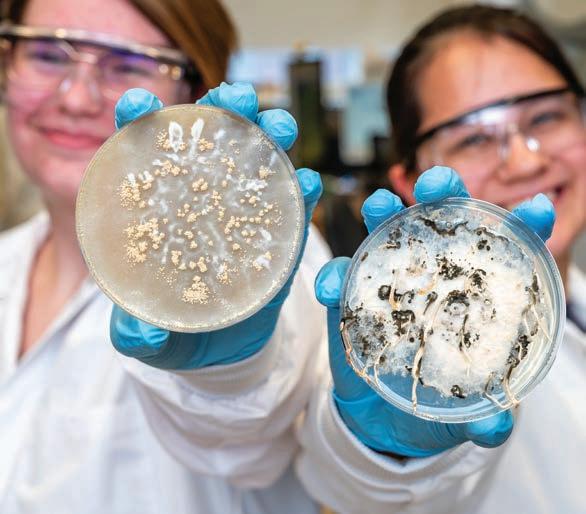

![]()


UNCG Research is published by the Division of Research and Engagement
UNC Greensboro
1111 Spring Garden Street Greensboro, NC 27412
336.256.0426
Vice Chancellor for Research and Engagement
Dr. Sherine O. Obare
Vice Chancellor for Strategic Communications
Diana Lawrence
Editor
Sangeetha Shivaji
Art Director
Jaysen Buterin
Photography Director
Sean Norona
Contributing Editor
Mark Tosczak
Associate Editor
Nikkola Brown
Graphic Designers
Jaysen Buterin, De’Andre Gilliard, Hunter Pham
Contributing Photography
Chris English, Martin Kane, David Lee Row
Contributing Authors
Robin Sutton Anders, Brian Clarey, Rachel Damiani, Chad Fogleman, Terri Relos, Dee Shore, Mark Tosczak, Alice Touchette, Elizabeth Witherspoon
Proofreaders
Nikkola Brown, Leah Jarvis
Distribution Manager
Haley Childers
UNCG Research is printed on an FSC and SFI certified paper. No state funds were used to print this magazine.

IN THE DARKROOM Associate professor Leah Sobsey and her students explore photography using light-sensitive pigments extracted from nature. This Earthen Door, a recent book and exhibit by Sobsey and collaborator Amanda Marchand, employs similar techniques to bring poet Emily Dickinson’s treasured collection of pressed plants to life. The work has appeared in museums nationwide and in prestigious media outlets including The Washington Post and ARTnews.


Mobilizing a new unit to benefit members of the military, from the battlefield to the classroom


New BRIGHT Institute nurtures North Carolina’s strengths in critical minerals, battery and energy technology

O
ne of the great privileges of my role is getting a first look at this magazine before it reaches our broader community. This issue inspired me with its stories of groundbreaking insights and tangible progress in human wellbeing. On campus and across our state, our faculty and students are creating new knowledge and putting that into action through innovative projects and programs.
I believe you’ll be just as inspired. UNCG is at a pivotal moment as we work to elevate our research enterprise to new heights. Our 2025–2030 Strategic Plan, adopted earlier this year, includes an ambitious and transformative goal: to achieve R1 Carnegie classification, the highest level of research excellence.
UNCG has long had a strong foundation in research across the physical sciences, health and wellness, social sciences, and humanities. Now, we’re building on that legacy to fully realize our potential as a top-tier research university.
My top priority is to support our faculty and research scholars as they lead discovery, spark innovation, and foster our national and international leadership in critical fields. To that end, we are launching a Research Leadership Academy to give researchers access to the tools, mentorship, and resources they need to lead cuttingedge, high-impact research.

ACHIEVING R1 STATUS WILL POSITION UNCG TO RECRUIT AND RETAIN WORLDCLASS FACULTY AND STUDENTS, DEEPEN PARTNERSHIPS WITH INDUSTRY, DRIVE ENTREPRENEURSHIP, AND DRAMATICALLY INCREASE OUR COMPETITIVENESS FOR EXTERNAL FUNDING.
THESE OUTCOMES WILL HAVE FAR-REACHING BENEFITS NOT JUST FOR UNCG, BUT FOR ALL OF NORTH CAROLINA.



More high-quality, better-paying jobs for students and alumni
Research that fuels innovation and spurs economic growth
Knowledge that improves health, security, and opportunities across our communities
Importantly, we will continue to fulfill our mission of advancing social mobility and expanding opportunity for the students and communities we serve. In doing so, we are bringing to life our vision to redefine the public research university for the 21st century.
The stories you’ll find in this magazine offer a vivid snapshot of that vision in action.
Our iCOMMAND initiative is making major strides in protecting and empowering members of the armed forces. Through research and tailored educational programs for veterans and active service members, we are contributing to their safety in deployment and their success after service.
Similarly, the new BRIGHT Institute will serve as a statewide hub for next-generation energy, battery, and critical materials research, and help train the workforce needed to power North Carolina’s fast-growing clean energy sector. With Toyota investing $14 billion in a battery plant that’s just 30 minutes from campus and expected to create 5,000 jobs, the BRIGHT Institute will prepare students and job seekers for success in this thriving industry.
Our researchers are exploring ways to improve health and wellbeing, from finding new medicines in natural products and new ways of safeguarding the environment to innovative mental health initiatives. Our multi-disciplinary efforts focused on energy will help keep North Carolina competitive globally as new technologies change how we transport goods and services and power our communities.
I invite you to explore these stories to learn more about the work our faculty and students are doing. This is just the beginning. I hope you will join us in supporting this exciting journey.

Sherine Obare Vice Chancellor for Research and Engagement

CURRENT ROLE:
Vice Chancellor for Research and Engagement
LAST JOB:
Dean, UNCG NC A&T Joint School of Nanoscience and Nanoengineering
EDUCATION:
B.S. in chemistry with a minor in biology, West Virginia State University
Ph.D. in chemistry, University of South Carolina
RESEARCH FOCUS:
Environmental contaminant detection and remediation; understanding of the fate, transport, and toxicity of anthropogenic nanomaterials; the development of nanoscale materials for alternative energy, biomass conversion, healthcare and drug delivery
Especially proud of her research on ways to defeat the growing problem of antimicrobial-drug resistance in bacteria, fungi, and other infectious organisms
ONE THING THAT SURPRISES PEOPLE ABOUT HER: Has lived in seven countries across four continents

Dr. Nick Oberlies’ lab searches for cancer-fighting compounds in fungi, delves into the chemistry of medicinal herbs, and explores how fungal chemistry could make electricity cheaper and safer.
It’s not often you get a surprise phone call from one of your heroes. But that’s what happened to Dr. Nicholas Oberlies in 1998. Oberlies, now a Sullivan Distinguished Professor of Chemistry at UNCG, was a professionally unfulfilled industrial chemist at the time.
The call was from Dr. Monroe Wall, a scientist at the Research Triangle Institute in North Carolina. Wall and collaborator Dr. Mansukh Wani discovered taxol, a widely used cancer drug, in the bark of the Pacific yew tree. They also isolated camptothecin, found in certain Asian plants, which became another cancer drug.
“They are like superheroes to me,” Oberlies says. “If you talk


to an oncologist, they will say that taxol changed the world.”
It’s the kind of work Oberlies had long dreamed of doing. That call brought him to the Research Triangle of North Carolina to work as Wall’s protégé and eventually to UNCG.
Now, Oberlies, assisted by dozens of students and researchers across the state, nation, and globe, is working on potentially world-changing projects. These range from searching for new cancer medicines to discovering how fungi-based chemistry could transform how electricity is generated, transmitted, and stored.
“The big idea in my research group is to understand the chemistry of nature,” Oberlies says. “People have the conception that nature is static – like a tree alone in the woods. But really, nature is sending out and receiving chemical signals all the time.”

Fungi grow on rice in flasks. “Each sample represents a unique opportunity to discover diverse chemical compounds,” says Oberlies.
Oberlies’ field of natural products chemistry historically focused on plants.
But plants come with challenges. Field expeditions to gather samples are time-consuming and expensive. Getting specimens back to a U.S. lab from other countries can be tricky. And growing plants takes resources – water, soil, greenhouses, and months of time as seeds or cuttings grow big enough for lab analysis.
Oberlies still works with plants. But he’s expanded his work to focus also on fungi – a scientific treasure chest full of novel, undiscovered chemistry that could help protect the environment and treat disease.
“In my lab, we are experts in isolating individual compounds from the mixtures of compounds that a plant or fungus produces,” he says. “Once we have those bioactive substances in a pure form, we carry out a multitude of experiments to figure out how the molecule is put together.”
The opportunities to discover new and potentially useful compounds from fungi are staggering. An estimated 90% of fungal species – millions – are undiscovered.
Dr. Huzefa Raja, who has worked in Oberlies’ lab since 2011 and leads the mycology or fungal biology side of the operation, says, “We discover new species all the time.” He estimates they have screened over 10,000 strains on their quest. “We find a new fungus. And it often makes new chemistry.”


Submerged wood sample from a freshwater habitat collecting trip.
Fungi are everywhere in the natural world – in the soil, in fresh and saltwater, in environments of every type. They play a critical role in breaking down organic matter, such as dead wood and leaves, and returning those nutrients to the environment.
“I love mycology because of the diversity of the organisms,” Raja says. “It’s beautiful.”
Raja’s domain is filled with Petri dishes full of fungi. Some were sourced nearby, such as on campus, and some far away, like one from a California beach.
Each species of fungus is an opportunity to discover new compounds with the potential to make life better for people.
The Oberlies lab collaborates with Mycosynthetix in Hillsborough, a company that has catalogued over 50,000 species of fungi for use by university and industry scientists. Founder Cedric Pearce is an adjunct chemistry professor and Coleman Foundation Entrepreneurship Fellow at UNCG. Oberlies is on the company’s scientific advisory board.

Raja mentors undergraduate April Joseph in the mycology lab.
In addition to penicillin, fungi have been the source for cholesterolreducing statins, antifungal drugs, a medication used to treat multiple sclerosis, and an immunosuppressant that transplant patients sometimes take to ensure their bodies don’t reject a new organ.
About 25 percent of all drugs are derived from nature; about 60 percent of anti-infectious disease and anti-cancer drugs come from natural sources.
But, Oberlies says, “There are no anti-cancer drugs derived from fungal metabolites – zero.”
Not yet, anyway. In an application for a project funded by the National Cancer Institute that netted the lab $2.7 million in research funds for 15 years, Oberlies wrote, “We strive to change that.”
Drug discovery is hard.
“We discover plenty of things that will kill cancer cells,” Oberlies says. “If you’re a mouse and you’ve got cancer – I’ve got you. But we haven’t gotten beyond that.”
In addition to finding something that successfully attacks cancer in humans, new drugs must overcome three other major barriers: supply, solubility, and patents.
“With any natural product, a major problem is supply. This was a huge problem with taxol,” Oberlies says of the yew-based cancer drug. “But, we can grow fungi easily, we can ferment fungi. Penicillin costs pennies because of that.”
The second issue: many natural products don’t dissolve in water. “They just don’t go into saline that you can inject in someone’s arm,” Oberlies says. “But there are techniques to get around that.”
The third issue is patents. To do the research and testing required to take a new compound from just “potentially useful” to “proven to safely and effectively treat disease in humans,” companies invest billions of dollars and years of time. They need patents that allow them to reap the rewards from financially risky drug development research.
But natural compounds can’t be patented. So, they must be altered in some way to make them artificial.
“Some of the development process is to make an analogue,” Oberlies explains. “You’ve made the natural product not natural – changed an atom, changed a side chain, to optimize certain properties, and you can suddenly patent it.”
Undergraduates April Joseph and Caitlyn Costello are researchers in the Oberlies lab under Raja’s supervision. “Maintaining all of the fungal strains is almost like having little babies in your lab –you constantly have to keep feeding them,” explains Raja. “April and Caitlin help the lab do that and help identify new strains by extracting DNA and conducting phylogenetic analyses.”
Joseph, a senior this spring, also worked on a project involving one of the unique compounds identified in the Oberlies lab. Forged solely in places where two fungi –Aspergillus fischeri and Xylaria flabelliformis – compete for dominance, wheldone is the product of fungal chemical warfare.
In collaboration with a pharmacology lab at the University of Illinois Chicago led by Dr. Joanna Burdette, the researchers have found that wheldone displays cytotoxic activity against breast, melanoma, and ovarian cancer cells in vitro.
“I’m working on producing the compound at a larger scale,” explains Joseph. The materials will be sent to their collaborators in Chicago for testing in mice.
“Research has given me the chance to think critically and contribute to something bigger than myself,” says Joseph. “It’s an experience that has truly shaped my future.”
The Oberlies lab has mentored nine postdocs, 22 graduate students, and scores of undergraduates.
“This is what the beginning stages of developing a fungal drug to treat cancer looks like,” says Raja. “We offer a very strong training ground for our undergraduate researchers, with many going on to prestigious graduate programs, professional schools, and the workforce.”
From supplement stores to gas stations, many herbal products are sold with the implication they can improve your health or address illness. There’s often little scientific backing for those claims.
Before scientists can assess whether an herbal remedy is effective, they must know what’s actually in it. That’s where Oberlies and Dr. Nadja Cech, a UNCG natural products chemistry professor, come in.
“Herbal remedies are a mixture. Sometimes they’re a mixture of five or six compounds, sometimes they’re a mixture of dozens of compounds,” Oberlies says. “If you’re going to study Herb X, I want to make sure that you actually know what the herb is.”
For the last decade, Oberlies and Cech have analyzed popular herbal products, including green tea, milk thistle, cinnamon, CBD, and kratom.
Kratom, for example, has been used in Southeast Asia, where the tree grows natively, since at least the 19th century to treat pain and other ailments. It is sold in many states and is legal and unregulated in North Carolina, although the FDA says kratom can’t be marketed as a drug, supplement, or food additive.

Tyler Graf leads the lab work on kratom, preparing materials, evaluating the chemical complexity of the samples, and sharing samples and data with collaborators around the country.
Dr. Mary Paine, a pharmaceutics professor at Washington State University, worked with Oberlies and Cech to prepare for the only U.S. clinical trial of kratom. One finding of that study was that kratom might increase the overdose risk among opioid users.
Interdisciplinary, collaborative research – like the long and productive partnership between Oberlies, Cech and other scientists investigating herbal remedies – is the norm for Oberlies.
His current funded projects involve industry, government, and university collaborations with the likes of Attagene, Inc., the USDA, Vanderbilt University, Boston University, and The Ohio State University, to name only a few.
“I always tell new students that want to join my group that we are extremely collaborative,” he says. “Everyone has a role to play. The role may grow over time, but no one person’s role is greater or lesser than anyone else’s.”
The latest initiative that has grown out of Oberlies’ lab started with a chance question by another professor in a departmental meeting.
A few years ago, Oberlies’ doctoral student Zeinab Al Subeh made a presentation to the faculty – a part of the graduate student training process in the Department of Chemistry and Biochemistry. They nurture rich scientific discussions that can blossom into new discoveries.
Dr. Shabnam Hematian asked the student about the “redox potential” of the fungal-derived compounds she was studying. Al Subeh didn’t know the answer – it relates to how efficiently the compound moves electrons around. However, she took the opportunity to explore the subject with one of Hematian’s electrochemistry-focused graduate students.
That started a collaboration to explore the potential of fungal chemistry in applications related to the generation, storage, and transmission of electricity. The collaboration has now bloomed into a rich, cross-university, cross-disciplinary research initiative called NICER – Nature Inspired Collaborative Energy Research.
The highly collaborative effort was kickstarted by a $1.5 million Research Opportunities Initiative – ROI – grant obtained by Hematian from the N.C. General Assembly to explore how compounds found in fungi might create greener energy systems. It’s now led by Oberlies and UNCG’s Dr. Minjeong Kim, assistant professor and associate head of computer science.
Many technologies we use to produce, store, and transmit electricity – everything from solar cells to electric car batteries – use lithium and other rare metals. Organic compounds, such as those produced by fungi, could potentially serve the same purpose.
The molecules in fungi have characteristics – such as the ability to dissolve in water and function in other chemical environments – that could make them useful in batteries and other electrical technologies. While new organic compounds are unlikely to replace materials like lithium entirely, they could reduce the need for them. New chemistry using organic compounds might also be more environmentally friendly.
The researchers say the NC ROI grant – the first ever secured by UNCG faculty – will help them conduct basic research, which could lead to federal funding. NICER collaborators include chemistry and engineering professors from UNC Charlotte, and UNC-Chapel Hill, as well as Mycosynthetix’s Pearce.
In addition to research on how fungal chemistry might be applied in electrical technology, the NICER funding provides training and educational opportunities for undergraduates, grad students, and postdocs, developing the state’s science and technology workforce.

Doctoral student Reema Al-Qiam is focused on a class of fungal-produced compounds called perylenequinones that could have energy applications.
Growing fungi in a Petri dish is one thing. Deciphering their unique chemistry, identifying useful substances and figuring out how to increase production of them is entirely different – that’s Al-Qiam’s job.
Since starting at Oberlies’ lab, she’s figured out how to ramp up production a thousand-fold – from a few milligrams to multiple grams that can be supplied to other researchers.
In addition to simplifying the process, the Jordanian student has discovered how to use more environmentally friendly chemicals to produce the perylenequinones.
Now, she’s focused on making changes to the molecule that affect its characteristics and behavior in different conditions, such as when it’s exposed to light of different colors. “I take the compounds from nature and try to improve the structures,” she says. “Right now, I’m adding something that increases light absorption.”
Penicillin changed the world. It and subsequent antibiotics remade medicine – extending average human lifespans by decades and turning once-deadly infections into, in many cases, mere medical annoyances.
“All of that started with a scientist making an observation in his lab. It was then picked up by chemists who isolated the molecule and figured out its structure. Then, teams of scientists developed ways to supply it at scale,” Oberlies says.
“A single observation, in a single Petri dish, followed to completion creates an antibiotics revolution.” That’s why he considers his work with students his most important contribution. “If we don’t train the next generation of scientists, who will do those kinds of experiments for the next 100 years?”
by Mark Tosczak

Last year, Oberlies received UNCG’s top research award for his scholarship in natural products chemistry. The past president and fellow of the American Society of Pharmacognosy has published over 250 research articles, has been cited over 19,000 times, and has acquired over $10 million in funding for UNCG from sponsors like the National Institutes of Health, Department of Defense, and American Cancer Society.
The big idea “Fungus does not make penicillin for the benefit of humanity. It makes penicillin to fight off bacteria that may encroach on its source of sustenance. Similarly, the walnut tree secretes juglone to prevent other plants from growing nearby and robbing it of resources. Nature constantly interacts via a gemisch – a mixture – of chemicals. It’s our job to turn that to our advantage.”
It takes a team “Collaboration is central to our research. Our collaborators are diverse, from an expert in ovarian cancer, to a microbiologist who studies drug-resistant bacteria, to a parasitologist who studies drug-resistant malaria, to experts in metabolism who study what happens in the gut when an herbal remedy is combined with a prescription drug.
“While those all seem like disparate goals, the common thread is that someone noticed an extract from nature did ‘something.’ It is my lab’s job to figure out what compound or compounds did that ‘something’ and then determine their structure or structures. When we have a very promising lead, we figure out a way to make the compound on a larger scale, to make analogues of the compounds to improve potency or minimize the side effects, and to determine the best way to deliver it.
“In all cases we work with teams of scientists across UNCG, the state, the country, and the world. Today, I just got off the phone with a collaborator in Chicago and emailed others in Washington and Ohio. Next week, I travel to Texas, next month to England.
“I’ve been playing soccer nearly my entire life, sometimes I use that analogy with my new students. In soccer, my role is the not-soglamourous left fullback position. But if no one is in that position, the game will quickly fall apart. Everyone needs to show up to play and be willing to work as a team.”
Paying it forward “I can go on and on with examples where mentors gave me a shot, provided encouragement, helped open a door. I cannot pay a single one of them back. The only thing I can do is try to pay it forward. Training the next generation of scientists is one of the key reasons I came to UNCG.
“I’m so proud of the scientists that have been part of our team and what they’ve gone on to do. Graduate students trained in our lab are now professors in Arkansas, Thailand, Jordan, Mexico, Saudi Arabia, and Turkey. Three of our students are now at Proctor and Gamble – one as a director, and we have past students at AbbVie, Edeniq, Integrity Pharmaceutical Advisors, KBI Biopharma, Sutro Biopharma, Syngenta, and Triclinic Labs. Others are research scientists at universities or pursuing the next step in their education as master’s and doctoral students at prestigious universities.” researchexcellence
For 15 years, Oberlies and his students have hosted a yearly Family Science Night at Lindley Park Elementary, to encourage a love of science learning in the community.

THE TEAM works with tenants twice a week in the Guilford County Courthouse in Greensboro.
UNCG researchers translate data and evidence-based frameworks on housing insecurity into action –working with local governments, nonprofits, landlords, and residents to reduce evictions.
Renée Norris, eviction mediation program coordinator for UNCG’s Center for Housing and Community Studies, says housing is a human right.
“Everyone who chooses should be able to have a place, however small or humble, that they can go and say, ‘I’m home. I’m safe.’”
But as a researcher and lawyer focused on housing issues, she knows things are not that simple. Rising rents and interest rates price many out of the market. There’s a lack of affordable housing, and many existing units are in sometimes-dangerous states of disrepair.
The Center for Housing and Community Studies, or CHCS, conducts research and community-informed interventions to tackle thorny problems exactly like these. Work ranges from a recent affordable-housing study in Baton Rouge to legal-needs assessments for low-income residents in South Carolina and North
Carolina, to an affordable housing plan for Gastonia. Norris’s Eviction Mediation Program focuses on Guilford County. As recently as 2016, Greensboro had the seventh-highest eviction rate in the country. Evictions impact renters and property owners and disrupt entire neighborhoods, says Norris.
50% of Guilford renters had trouble affording their homes (NC Housing Coalition)
For example, a recent Legal Services Corporation study determined that eviction proceedings are rarely beneficial for landlords, costing $2,500–$8,000 per case and resulting in fewer than 10% collecting owed back rent.
Through education, advocacy, and intervention, the CHCS eviction mediation program – a collaboration between UNCG and Legal Aid of North Carolina – benefits the entire community.
“We partner together twice a week in the Greensboro courthouse and twice a week in the High Point courthouse,” explains Michael Cheema, a Legal Aid attorney. “Tenants can come to our table and receive mediation services, get connected with affordable housing, or get matched with a lawyer.”
the word’sout

In three years, project personnel worked with
3,771 tenants at courthouse clinic days
2,985 clients outside of clinic days
“Sometimes we will see someone in court because they owe $1,000 or $2,000 – mostly due to a job issue, either reduced work hours or losing their job,” Norris says. “By the time they get the new job, they’re already a month or two behind. Or it’s a temporary health issue.”
Rental assistance and mediation make a big difference in these cases.
Cheema has been deeply moved by the program’s impact. “So many of my clients describe facing eviction proceedings in court as one of the most humiliating experiences of their lives – or scariest. The center does a lot of work to stop things from having to go to court, so tenants don’t have to go through that.”
For example, CHCS Landlord Outreach Specialist Tara Tillman uses her real estate background to connect with landlords. “Our goal is to find out what they’re thinking and explain mediation and the voucher system, and how that can benefit them,” Norris says. “It’s a hard climb, but she speaks the language.”
The center’s list of housing vacancies in Guilford County is also more accurate and complete than the one posted by NC Housing Search.
During the early years of COVID, Norris says, evictions declined because Greensboro and Guilford County won American Rescue Plan Act Emergency Rental Assistance program grants that helped people stay housed.
Pandemic-related funds mostly dried up in 2023, but the problem of eviction remains. In recent years, Norris has seen rents rise and other troubling trends.
She says fewer landlords are accepting federal Section 8 rentalassistance vouchers from low-income renters. Meanwhile, rental-pricing software tools can push rent to upper limits, while aggressive bargaining and cash purchases by investors make homeownership less accessible. The rise of corporate ownership of rental properties further stresses the system.
“They don’t give property managers a lot of leeway,” Norris adds. If a corporate policy says no partial payments, for example, mediation is out the window. “They don’t have the sense of community, or the sense of investment in our community.”
Guilford County’s homeless population largely tracks with the rise and fall of the rental-assistance programs.
An annual point-in-time count shows a high of 721 people experiencing homelessness in Guilford County in 2016 – 129 of them under 18. The total number dropped to 452 in 2023 but rebounded to 665 in 2024.
Homelessness, Norris says, becomes a community problem when people are forced to live on the street.
Businesses that rely on employees getting to work, on consumers with dependable income, and on safe streets to engage in commerce have as much of a stake in this as local government, neighborhoods, and community organizations do.
“We’re never going to solve anything by thinking of the other side as the enemy,” Norris says.
“We need the landlords. And they need the tenants. We need to realize that we all have valid points of view, and that none of us want people to live on the street.”
by Brian Clarey
With tools like Unreal Engine, UNCG faculty and students are stretching the boundaries of creativity and innovation and developing cutting-edge production techniques, augmented performances, and new media experiences.

UNC Greensboro has long been a destination for arts students. Now it’s also a portal into virtual arts careers in the gaming, media, and technology industries.
Innovate UNCG – the university incubator for entrepreneurship – is helping lay the groundwork for techforward growth in the College of Visual and Performing Arts, or CVPA.
“To have a viable career as an artist in the 21st century, you need a broad and dynamic skillset,” says one of Innovate UNCG’s leaders Dr. John Borchert. “UNCG is a place to learn and create things in an advanced technological space.”
Inside the Gatewood Studio Arts Building, a state-of-the-art studio provides animators with equipment for 2D, 3D, and interactive projects. The new lab, part of the BFA Studio Arts Animation Concentration, gives students an industry-standard workspace.
The animation concentration, just two years old, has 35 students and adds about 10 students each semester. As the program grew, faculty pushed for a dedicated lab.
“Everything we have now is what you would experience at an animation or game studio,” says School of Art Associate Director Heather Holian. The Disney and Pixar scholar, along with professors Dan Hale and Rodgers Dameron, is expanding the program and facilities to meet growing demand.
That includes bringing in advanced game and animation software like Unreal Engine and the high-performance PCs it requires. “These computers are absolute workhorses,” says animation undergraduate Finley Lewis.
This spring, Innovate UNCG also installed an LED Volume wall in the Department of Media Studies to train students in the latest video techniques. The top-of-the-line virtual production technology located in Carmichael Building is 3D, animated, and interactive – the game engine powering it moves the background with actors’ movements. The technology is used in everything from local news to Disney productions such as The Mandalorian.
“Animators and digital designers develop virtual environments to display on the curved screen of linked LED panels – which can be 50 by 20 feet in the movie industry,” explains Borchert. “With tracking technology, when actors in front of the wall move, the scene moves, casting real lighting on the actors and making it seem like they are moving in the virtual space.”
Holian envisions UNCG as a destination school for animation. “We provide a top-notch education. Our students deserve and are getting access to this industry.”

“Animation is everywhere – in film, gaming, medical fields, and beyond,”
Hale says.
“There is profound interest, and our classes are full – with waitlists.”
This winter CVPA launched an Innovate UNCG Impact through Innovation – ITI – Hub to foster innovation and entrepreneurship within artistic disciplines.
Four faculty fellows from each of the college’s departments – art, music, dance, and theatre – are building a business and entrepreneurship skills course, for launch this fall.
“If we are training students in the arts, we need to give them business skills as well. Otherwise, we’re sending them out unprepared,” says Hannah Grannemann, associate professor of arts administration and CVPA ITI Faculty Fellow. “Artists can’t get their work seen and sold in the world without entrepreneurial skills and confidence.”
The CVPA hub joins recently established ITI hubs in the School of Education and the School of Health and Human Sciences. The goal: an interdisciplinary network of innovators across campus.
“Every discipline has its own set of priorities and curriculum,” says Borchert. “The newest hub is designed to create platforms unique to the ambitions of CVPA students.”
UNCG leads peer support, other programs to improve North Carolina mental health
Anxiety, depression, and other mental health conditions are becoming more common among N.C. children, creating painful challenges for them and their families.
How do they find a therapist and support their child? For many families, there’s no clear roadmap after a child receives a diagnosis or experiences a crisis.
UNCG is leading efforts to change that – implementing the state’s plan to expand peer support as well as provide other critical services – and contributing to the national understanding of best practices.
“The N.C. Department of Health and Human Services (DHHS) recently released a strategic plan, and peer support is a focus of how they want to move forward,” says Willow Burgess-Johnson, a licensed clinical social worker with the UNCG Center for Youth, Family, and Community Partnerships (CYFCP). “It’s becoming integrated into North Carolina’s vision for the mental health care system.”
Peer support specialists are trained community members who’ve often had experiences similar to those of the people they’re helping. They provide a sympathetic ear and guidance for families and children navigating the mental health system. UNCG’s work is putting North Carolina on the map as a leader in this promising new approach.
Two CYFCP programs – UNCG’s NC Youth and Family Voices Amplified and NC Healthy Transitions – are training
The hubs also bring innovators across campus together to explore strategies for scaling ideas. The aim is for all disciplines to consider entrepreneurship and social innovation as they work to address challenges in their fields.
UNCG has also become one of just 36 U.S. universities with an Unreal Academic Partnership with Epic Games. The Carybased company developed the Unreal Engine 3D computer graphics tool and Fortnite, one of the world’s most popular video games.
Faculty in UNCG’s Unreal Fellows program will integrate the tech into teaching and research, leveling up interactive and simulation media at UNCG. “Uses for engines like Unreal began in the gaming industry but extend far beyond that now,” Borchert says. “Now we’re looking at biotechnology, aviation, and more.”
by Alice Touchette and Terri Relos

and integrating youth and family peer support specialists into programs across the state.
With $4 million in new funding from DHHS, NC Voices Amplified will train 40 new certified family peer specialists. It’s also working with the National Federation of Families on best practices for peer support and will collect data to measure the impact of family peer support.
Some of these youth peer support specialists may plug into NC Healthy Transitions, which supports 16- to 25-year-olds who have mental health conditions as they transition to adulthood, providing counseling, vocational support, and more. The U.S. Substance Abuse and Mental Health Services Administration recently awarded NC Healthy Transitions $3.75 million to bring the pilot program to Burke, Catawba, and Iredell counties, in collaboration with Children’s Hope Alliance.
“I’ve worked in mental health for a little over two decades now, and there have been many days where I felt discouraged – there’s always more need than there are resources,” Burgess-Johnson says (above with Family Training Coordinator Frederick Douglas). “But this area feels exciting, creative, and innovative. It feels hopeful to me.”
by Rachel Damiani

UNC Greensboro is calling up its strengths in research and education to mobilize a new unit benefiting members of the military – from the battlefield to the classroom.
iCOMMAND, or the Institute for the Convergence of Optimized Methods for Military Advances and National Defense, focuses on four strategic areas:
Protection through innovative material and design
Holistic performance through health and wellness
Advancing biotechnology
Education and workforce development
Vice Chancellor for Research and Engagement Sherine Obare says the new UNCG institute will leverage existing research and relationships and forge new connections to ensure members of the military, and their families, thrive in any environment and in every phase of their lives.
“We want to enhance North Carolina’s position as a national leader in innovation in materials science and technology to support and protect service members,” says Dr. Obare. “We also want to coordinate our efforts in education, training, and workforce development to support military-affiliated students.”
The university is already partnered with the U.S. Army Combat Capabilities Development Command Soldier Center – and with
other universities in a system-wide effort – to develop innovative ways to protect soldiers from threats.
UNCG researchers are also connected with service members and veterans on base and on campus to develop and deliver health and wellness interventions that improve their well-being and resilience.
At the university, 8% of students are military-affiliated, and UNCG is a Top 10 Military Friendly School for both veterans and military spouses.

Interventions for these students flow through the UNCG Military-Affiliated Services office, known as MAS by staff and students. There, dedicated staff and faculty support past, current, and future service members, plus their dependents, in accessing educational benefits, getting academic support, and finding a community. These UNCG offerings, which ease the military-to-college transition, leading to greater student success, are spreading across the system and, researchers hope, will set new standards for the nation.
iCOMMAND will help amplify these innovations at UNCG, says Obare. Through the new institute, the university formally sets its sights on equipping members of the military with advanced protective technologies, supporting them through science-backed training, and providing transition support for life after service.


In 2022, ICONS, the Innovative Collaborative Laboratory for Nanotechnologies to Empower the Future Soldier, launched as a collaboration between the UNCG and NC A&T Joint School of Nanoscience and Nanoengineering and the U.S. Army Combat Capabilities Development Command Soldier Center.
With over $1 million in funding, ICONS is developing specialized fabrics, material additives, sensors, and devices to protect soldiers and improve their performance in extreme environments.
“We are manipulating materials atom by atom to enhance soldiers’ safety, agility,

and endurance with stronger, more flexible, and comfortable textiles,” Obare says. “It’s about how we can improve their clothing, masks, backpacks, helmets, and more.” Nanoscientist Dr. Tetyana Ignatova (above, center), co-leader of ICONS and a national leader in integrating artificial intelligence and nanoscience, conducts research focused on altering the properties of materials to help protect soldiers. Her team’s mission: to develop nanomaterials that are lighter, stronger, and safer.
They are working on new nanomaterials for thermal protection devices, chemical and biological agent sensors, flexible electronics incorporated into fabrics, modified aquatic plants to clean up pollutants, and enhanced antimicrobial substances.
“This project gives students a unique opportunity to work with the government on real-life problems –sometimes of national importance,” Ignatova said. “This partnership with DEVCOM Soldier Center helps bridge the gap between fundamental research in the lab and applied technology, ensuring our work supports U.S. defense needs.”

UNCG’s defense work has also attracted interest from the state. In 2023, UNCG, with collaborators at NC A&T State University, Fayetteville State University, and Winston-Salem State University, won a UNC System Research Opportunities Initiative grant for the “Next Generation Protective Materials for Soldier Empowerment – NextGen PROMiSE” project, to expand North Carolina’s investment in this area.
Each of these research projects is also a training ground for the next generation of scientists. National Science Foundation Graduate Research Fellow and doctoral student Garett Barto is a scientist in training and a captain in the U.S. Army Reserves.
When he’s not in the lab researching Bacillus anthracis, the deadly bacteria that causes anthrax, Barto is responsible for 21 Army Reserve drill sergeants and trains cadets at military institutes, among other duties. Barto works in Dr. Jason Reddick’s biochemistry lab. His bioinformatics project analyzes the genome of B. anthracis to discover
new and unique enzymes that might be repurposed for industry or biodefense applications. Barto’s dream is to conduct chemical and biological weapons defense research at the U.S. Army Medical Research Institute for Infectious Diseases.
UNCG’s MAS, he says, has helped unlock educational opportunities, helping him figure out the best way to use his GI bill benefits for doctoral credits.
“Being the only military doctoral student in my department can be lonely, as my life experiences are very different from most of my peers,” he says. MAS has also helped him find a sense of community.
“I believe defense against harmful chemicals and diseases is extremely important for our society,” Barto says. “I want to be the person to step up and learn how to contribute to that.”




A cornerstone of iCOMMAND is health and wellness research to improve the readiness and resilience of active-duty military. This also means deploying support for UNCG’s 1,600-plus military-affiliated students. Dr. Erin Reifsteck and Dr. Michael Hemphill, associate professors of kinesiology, are leading the charge, in collaboration with MAS Director Chris Gregory.
Military-affiliated students have distinctive practical, physical, and psychological needs.
In 2021, Reifsteck and her research team implemented a survey, focus groups, and interviews at UNCG to better understand student veterans’ experiences and how UNCG could better support them. Then, in 2023, she and Hemphill partnered with the UNC System Office to build on that study and assess students across the system.
Across the UNC System, the researchers discovered that half of student veterans report struggling with the transition from military to college.
Gregory notes the military provides activeduty service members wrap-around support: housing, health care, convenient on-base grocery shopping, credit unions, and more. New veteran students need to know where to find those services in the civilian community while also transitioning to a collegiate lifestyle.
“We also learned that student veterans valued being a part of a community with others and were shaped by their shared experiences through military training,” Reifsteck says. “The strong peer network was lost when they left the military, and many of those we surveyed wanted to connect with other student veterans.”
At UNCG, MAS’s suite of offices and gathering rooms serve as military-affiliated students’ go-to source for information to help them meet their needs, whether they are academic or personal. Home to an active chapter of the Student Veterans of America, it’s a popular spot for veterans to relax between classes, study, and connect with peers.
“The students need to know they are not alone,” Gregory says. “There are people who can answer their questions and point them to resources.”
The team’s research is helping optimize the services MAS offers.
“Students wanted better options for connecting with other military students, more contact with faculty, and online options for resources,” Reifsteck says. An expert in sport and exercise psychology, she was recently named the first UNCG Faculty Fellow for Student Veteran Wellbeing.

With a team of student veterans assisting, Reifsteck and Gregory recently launched the “Mail Call!” online platform where UNCG military-affiliated students can connect, seek answers to practical questions, find exercise or study partners, learn about events, and access other resources.
“The student veterans picked that name and took the lead in building it. It’s similar to the concept when soldiers receive mail from loved ones, and it’s like a meeting place to get your news, and it’s a positive thing,” she says. “Centering student veteran voices through the process has been extremely important.”
Reifsteck and Gregory have also developed training for faculty and staff to learn more about the military-affiliated student experience. By understanding students’ issues and concerns, faculty members can better empathize and assist these students.
“Transitioning from military service to university life is a really important period,” Reifsteck says. “University faculty and staff can better support the student veteran population – not only their student success, but their overall well-being.”

Physical fitness is basic to military success and vital to well-being. However, Reifsteck and Hemphill’s studies revealed that student veterans are less physically active post-service.
In the researchers’ system-wide survey, many student veterans also reported chronic pain, anxiety, depression, post-traumatic stress, migraine headaches, and insomnia. These are areas, the researchers say, where regular physical activity can help.

As a result, MAS has partnered with UNCG Recreation and Wellness to offer more fitness opportunities for its students. MAS also offers community-building events featuring physical activities, such as Veteran and Family Day at the Lake each semester. And they’re collaborating with the School of Health and Human Sciences on activities designed for double duty – to build fitness and community
In 2015, Reifsteck and her collaborators launched the Moving On! Program with the National Collegiate Athletics Association to prepare student-athletes to make healthy transitions to life after college sports. It’s now used at over a dozen NCAA-member institutions while an online module impacts thousands of additional studentathletes. Similar to college athletes, she says, military veterans also leave a highly structured, fitness-oriented lifestyle and need support adjusting.
Now, with the assistance of UNCG graduate student and veteran Casey Harrell and others, Reifsteck is retooling Moving On! for student veterans. Through the program, veterans will set personal nutrition and fitness goals, learn strategies for healthy eating and physical fitness, and develop customized plans that support their well-being.
Reifsteck is also involved in a multi-institution collaboration to help active-duty service members at Fort Bragg maintain physical readiness. That team is testing a mobile app using place-based notifications to improve health behaviors.
Always on the lookout for new ways to collaborate, Reifsteck shares what she’s learned from her research with fitness employees at the base. Many of them, it turns out, are UNCG alumni.
by Elizabeth Witherspoon and Alice Touchette

Libraries can transform communities locally and globally, says Dr. Noah Lenstra.
Wherever you are, even if you don’t have a car or access to public transportation, there’s a good chance you can get to a public library.
“The average American lives within 2.1 miles,” says the associate professor of library and information science. That stat powers his mission.
Since 2016, Lenstra has helped libraries in America and around the world boost healthy living in their communities through his “Let’s Move in Libraries” initiative.
In just the first two years, the movement drew libraries from every state and every Canadian province.
The website has nearly 50,000 visitors, 14 percent outside the United States. Lenstra has been invited to speak about the work in the United Kingdom, Taiwan, and Australia.
Lenstra has always understood the power of libraries as a jumping-off point to a bigger world.

As a child growing up in northwest Illinois, he played video games in his local library. “In the ‘80s, there was nowhere else you could access a computer,” he remembers.
He had his lightbulb moment as a doctoral student experiencing difficulties with his own health. “My chiropractor told me, ‘You can keep coming in here, but it won’t do any good unless you get at the root cause.’”
ON THE HORIZON Lenstra’s latest project, with public health researchers at the University of Pennsylvania, explores how public libraries can help combat the opioid epidemic.
Lenstra’s resulting quest for fitness opportunities led him to the discovery that, across the country, libraries were offering access to streaming fitness classes.
“In a lot of rural communities, senior centers and gyms don’t exist. But if you could get to a library, you could take a Go4Life class, offered online through the National Institute on Aging,” Lenstra says. “These classes were easy but effective – think strength training you can do in a chair.”
The classes illustrated just how effective libraries could be in connecting wellness information and opportunities to community

members. Lenstra launched Let’s Move in Libraries to share these findings – and grow the library health movement.
“Public libraries are beloved for three reasons: space, information, and reading,” he says. “Let’s Move in Libraries focuses on the space aspect. We see librarians transforming their own spaces and the spaces of their broader communities.”
With over 4,000 subscribers, the Let’s Move newsletter communicates health initiatives ranging from Geri-Fit at the Library classes to StoryWalks – community park trails where families on a stroll can read illustrated children’s books, page by page at stops along the path.
“The StoryWalk resource page alone has over 23,329 visitors,” Lenstra says. “We do an annual StoryWalk celebration with the Association of Bookmobile and Outreach Services.”
Lenstra’s mission for Let’s Move is two-fold: For librarians to find inspiration on preventative health, physical activity, and nutrition programs. And for health advocates to reach more people. “Whether you’re a yoga enthusiast or Zumba professional, I want you to think of librarians as people who can help you go deeper in communities – I want these groups to work together to amplify their impact.”
On social media, the collective Lenstra is building is over 6,500 strong. Their efforts are making libraries places for community transformation.
He carefully reviews comments program attendees leave online. His favorite: “We all need each other – as well as a physical time for our bodies!”
by Robin Sutton Anders

Acoral colony is a freak of nature.
Millions of tiny coral polyps form massive underwater reefs, but they couldn’t do it without their symbiotic algae partners and the bacteria and viruses that live among them.
Corals embody a host of conundrums for the scientific thinker. How do we define an individual “coral”? Where does one organism begin and another end? How do these creatures complicate our understanding of evolution, which traditionally views individual organisms as the unit of selection? What can corals teach us about other organisms where the whole is greater than the sum of its parts? Like, for example, humans.
“I just love weird things that break our common notions about biology,” says Assistant Professor Derek Skillings, grinning through his wild beard.
Skillings is the lead investigator on a new $600,000 grant – the largest in the history of

UNCG’s Department of Philosophy – from the John Templeton Foundation.
“The Emergence and Evolution of GoalDirected Behavior in Collective Entities” is his second Templeton grant. The first focused on understanding holobiont systems.
“A holobiont is a term for a host organism and all of the things that live inside of it and on it,” explains Skillings, who also holds adjunct positions in biology and in geography, environment, and sustainability.
“We used to think these weird things like corals, lichens, and maybe certain insects, which are amalgamations of symbioses, were the exception in nature. But now we are realizing, no, actually, it’s probably everything. Everything is a holobiont.”
Skillings points to the bacteria in our guts and on our skin, even the mitochondria in our cells, as evidence that humans – like coral and cows – are holobionts. From one perspective, a human is a unified organism. From another, we are an ecosystem unto ourselves.
“Understanding symbiosis and the coevolutionary dynamics of host microbiomes is critical for understanding human health, diet, and development,” says Skillings.
As with a coral reef, the complexity of the project requires different specialists. Skillings has assembled experts in mathematics, game theory and economics, and the philosophy of biology from different universities to aid him in examining how collective entities like ant colonies, corals, or human societies, behave and evolve.
Like the creatures that fascinate him, Skillings defies easy classification. As a firstgeneration college student, he approached graduation with majors in biology, chemistry, and philosophy, unsure of what path to take.
“I figured I could always do philosophy on the side,” he says of his initial choice. “It’s harder to do marine conservation genetics and coral reef biology out of my garage.”
As he explored deep-water reefs on month-long research cruises, Skillings grew more interested in philosophical questions about “biological individuality” and the “species problem” – how to distinguish between types of organisms. He wound up with doctorates in both biology and philosophy.
Today Skillings considers himself a philosopher of biology, whose experience with field research and genetic analysis grounds his philosophical work.
The Templeton funding supports yearly interdisciplinary workshops to broaden the conversation. “They’ve become prominent events, drawing scholars from across the world.”
Skillings sees the shop talks as “serendipity generators.”
“When you bring people together like this, you make space available for cool things to happen. You come up with solutions you hadn’t imagined.”
by Chad Fogleman

UNCG researchers bring research-based strategies to support parents and babies, from infant nutrition to healthy child development
How and what infants eat has profound and long-lasting effects on their health and well-being – including obesity rates and how vulnerable they are to illness and chronic health conditions as they grow older.
Around the world, an estimated 37 million children are obese, as well as a growing share of adolescents and adults.
But many questions remain about the pathways through which feeding and nutrition influence child development. UNCG researchers are leveraging cross-disciplinary expertise to answer those questions and develop evidence-based strategies to improve maternal and child wellbeing.
These scientists are lowering barriers to breastfeeding, improving the safety of donated breast milk for preterm infants, and uncovering which feeding practices lead to infant and child weight gain. And, ultimately, they’re improving nutritional outcomes, early life development, and long-term health, here at home and across the globe.
It’s no secret to most parents that breastfeeding is tough. But popular culture tends to present this critical activity as effortless and intuitive – setting some parents up for a surprise when they face barriers, including lack of time, support, and confidence, as well as physical limitations.
Dr. Jasmine DeJesus, an associate professor in psychology, recently experienced difficulties breastfeeding her first child. “I just have one experience with one kid, but it’s really opened my mind up: What are the bigger range of experiences?” she asks.
Now, DeJesus and Professor Jigna Dharod in nutrition are leading a $784,369 NIH-funded trial to reduce the barriers Latine parents face when breastfeeding.
It’s a needed project with trickle-down impacts that can help address the high obesity rate among U.S. Latine children. Almost half of the adult U.S. Latino population is obese, and infant nutrition serves as the foundation for lifelong health.
Formula feeding is linked to rapid weight gain in infants, which is in turn linked to childhood obesity and to lifelong obesity, the researchers say.
In a 2023 study of low-income families, Dharod and DeJesus found that infants who were fed only formula had three times higher risk for rapid weight gain.


“Infancy is a very important life stage. It’s a highly developmental phase, and it’s a phase of immense opportunities,” Dharod says. “At the same time, any vulnerabilities during this phase can have a lifelong impact.”
In their latest investigation, the researchers want to know whether peer counselors and financial compensation can help increase parents’ confidence in continuing with breastfeeding.
“Previous literature shows that many times a mother’s intentions are to continue with breastfeeding, but they stop,” Dharod says. “One of the key predictors of this is low self-efficacy, or confidence, in their ability to breastfeed.”
Finances and government policies can also play a role. Through WIC – the U.S. Department of Agriculture’s Special Supplemental Nutrition Program for Women, Infants, and Children program – low-income parents can opt into different packages for breastfeeding or formula feeding.
“The monetary value of WIC’s breastfeeding package is much lower than the formula assistance package,” Dharod says. “With formula assistance, families receive a few hundred dollars’ worth of infant formula. Exclusively breastfeeding mothers receive supplemental foods worth about $75.”
DeJesus and Dharod designed their trial to provide needed support to parents looking to breastfeed more.
“What’s most novel about our approach is to have culturally matched and bilingual peer counselors,” says DeJesus. “A peer counselor, especially one who speaks the same language as participants, can provide knowledge that can be helpful in navigating challenges.”
Strengths of this project include its community connections and involvement of dedicated UNCG students. “It’s possible because we have partnerships in place to reach hard-to-reach populations,” Dharod says.
Dr. Marjorie Jenkins, Cone Health’s system-wide director of nursing research, works closely with the UNCG team.
“Through this research, we’re ultimately changing lives as we discover new ways to make a difference in the communities we serve,” Jenkins says. The researchers say they feel the university’s alignment with their work.
“There’s a lot of support for community-engaged research at UNCG,” DeJesus says.
“I think in other places people feel more stifled – like it’d be more of a risk for them to take on a project like this because their university may not value all the work it takes to cultivate these connections, but we have had this opportunity.”
Spanish-speaking undergraduate and graduate students are also part of the research team, translating materials and recruiting mothers.
Selena Villa, a master’s student in nutrition on the project, has conducted research with Dharod since she was a sophomore at UNCG.
“I didn’t know you could do research like this as an undergraduate, and I was just shocked,” Villas says.
Dharod and DeJesus are equally appreciative of the student researchers.
“They can be cultural brokers and help us bridge that gap and build trust,” Dharod says.
“It’s a win-win situation for the research, the student, the community, and UNCG.”
The researchers say they hope to build this work into a future larger-scale trial.
“In addition to learning something scientifically, we also have the power to actually help people,” DeJesus says.
“That’s something that’s really exciting to me.”

In a UNCG study on the psychological, biological, and social factors linked to rapid infant weight gain, researchers followed 299 women and their infants from pregnancy to toddlerhood and found that infant feeding practices associated with obesity, known as obesogenic practices, play a central role.
Examples of obesogenic practices described in their recent Pediatric Obesity paper include watching television while feeding a baby, formula feeding, and supplementing a bottle with additional foods.
“The key take home point is that what and how parents feed their infants in the first 6 months of life has tremendous implications for obesity risk. Moreover, childbearing parents who experience more stress during the prenatal period are particularly likely to engage in these unhealthy practices,” says Dr. Esther Leerkes.
The Jefferson-Pilot Excellence Professor in human development and family studies served as lead author on the paper. Coauthors included Dr. Cheryl Buehler and graduate student Yu Chen in the same department as well as Safrit-Ennis Distinguished Professor Laurie Wideman in kinesiology and Dr. Lenka Shriver in nutrition.
Infants who gain weight rapidly before the age of two are at a higher risk for childhood obesity.
This set of findings is the most recent publication from UNCG’s NIH-funded Infant Growth and Development, or iGrow, study – a $2.8 million longitudinal research program to better understand children’s obesity risk by tracking infants’ biological and social development from before birth until age two. The first aim of the iGrow study focused on determining the main predictors of infants’ rapid weight gain by studying infants from before birth to approximately six months of age.
Researchers recruited 299 pregnant women and measured their physical and psychological health, known as prenatal psychobiological risk.
The researchers discovered obesogenic feeding practices strongly and significantly correlated with infant rapid weight gain, and that mothers’ prenatal psychological risk increased the likelihood they would engage in obesogenic feeding.
While the findings highlight the importance of parents reducing obesogenic practices, Leerkes says it is important to understand barriers families may face with infant feeding.
“Parenting a baby is so challenging. Parents are frequently exhausted and overtaxed between family and work commitments and ongoing stressors, and they are presented with lots of information which can be hard to weed through.”
Although breastfeeding is recommended to decrease obesity risk, some parents may not have this option due to time constraints, physical limitations, or other systemic level barriers.
“A variety of factors, including cultural and socio-environmental, can make it difficult for some women to breastfeed their babies,” says Shriver.
“Our findings show that new parents can still prevent excessive weight gain in the first few months of their child’s life even if breastfeeding is not a realistic option for them.”
They recommend parents who are bottle feeding stay attuned to their baby, including watching for signs their baby could be full, observing suckling rate, and turning off the television. They also advise parents to avoid adding cereal, juice, or baby food to a bottle and to try not to use a bottle to soothe a baby that is not hungry.
The new publication represents the first set of findings testing one of iGrow’s primary aims, and the researchers look forward to many more to come.
With an additional $3 million in NIH funding, the iGrow study recently expanded to include iGrowUP. Now, UNCG researchers are following participants all the way to the age of five, giving them a unique, longitudinal vantage point into obesity risk throughout infancy and early childhood.
UNCG Senior Jahleen Gourdine has a bright smile, sunflowers on her shirt, and steadfast determination to become a dietitian.
She’s the picture of a standout student – excelling in her human nutrition and dietetics major and receiving multiple awards, including the Louise E. Lowe Scholarship. But Gourdine’s path to where she is today was bumpy.
Gourdine initially attended college after graduating high school in 2018 but left before receiving her degree.
“I was kind of in this limbo state. I didn’t really know what to do with myself,” Gourdine says. “But then I found this lifestyle of being vegan and very cautious about our footprint, and it led me down this nutrition path.”
Since then, Gourdine has been dedicated to dietetics, accumulating over 1500 hours as a dietary aide and supporting herself through school by working most nights as a registration specialist in the emergency department.
Now she’s engaging in undergraduate research focused on childhood obesity for her senior honor’s project thesis under the guidance of nutrition professor Dr. Lenka Shriver, one of the leaders on the iGrow study team.
Shriver has a specific interest in children’s appetite behaviors and how eating in the absence of hunger – such as snacking on junk food when the child has already had a full meal – can contribute to obesity.
“The studies that exist in older children suggest a positive association between eating in the absence of hunger and weight outcomes, but we really don’t have studies looking at toddlers or in longitudinal models,” Shriver says.
“There’s a lot of work that needs to be done. I’m excited that Jahleen is able to dig deeper into our iGrow data and start looking at this young age.”
Gourdine is working with Shriver to analyze which factors, including socio-demographic characteristics and feeding practices, are associated with some toddlers eating more than others in the absence of hunger.
From analyzing data to writing a project abstract, Gourdine says participating in research has been a learning curve.
“Dr. Shriver has pushed me to write better and pay attention to how I’m reading these research papers. I really enjoy that,” Gourdine says. “I’m very thankful.”
Shriver describes Gourdine as a dedicated, organized, and goaloriented team member. Over the past year, she says, she’s enjoyed watching Gourdine embrace research and grow in her skills. “It’s a great example of the role research funding plays in shaping and strengthening our state’s workforce.”
Gourdine plans to enter a master’s program in nutrition. She says she’ll carry her training with the iGrow team into her career as a dietitian.
“Being a part of research has shown me the groundwork, evidence, and real people behind those numbers,” Gourdine says. “As a dietitian, it makes my recommendations a lot more credible.”

WHEN SHE BECAME INTERESTED in nutrition and sustainability, Jahleen Gourdine decided to give college a second try. Now she’s graduating with uncommon nutrition research experience and plans to pursue a master’s degree.



Donated human breast milk, or donor milk, is in high demand. For babies born prematurely to a parent unable to provide breast milk, it can even be a matter of life and death.
These preterm babies are at a high risk for a potentially fatal gut infection, necrotizing enterocolitis, and being fed breast milk can improve their odds. When parents are not yet able or unable to breastfeed, donor milk can be critical.
But, contrary to popular belief, not all breast milk is the same.
“There’s millions of very vulnerable babies being fed donor milk, but we don’t know what it is nutritionally,” says UNCG associate professor of nutrition Maryanne Perrin. “It’s not a consistent product, and we don’t understand the sources of variation.”
In Dr. Perrin’s laboratory, she’s working to unravel these differences in donor milk: a problem she’s well-suited, and arguably the first, to address. Perrin worked as an industrial engineer for years before going back to school for her doctorate in nutrition after having children.
“This is nutrition science, but it’s also the industrial engineering processes of making donor milk,” Perrin says. “I never imagined finding a field that brought together the first and second halves of my very different careers.”
If you thought all donor milk is the same, you’re not alone. Perrin says it’s a common misconception, even among medical professionals.
While some aspects of breast milk are similar – all have a high level of lactose – other nutrients vary. Mothers’ genetic differences contribute to some of the variations, she says. Timing of the donation may also play a role.
“If you’re an infant and born preterm, we’re pretty sure that your mother’s milk is going to be higher in protein than a mother who gave birth at term.”
After milk is donated, the storage and pasteurization processes can also cause changes to the milk, such as less fat from container
transfers and a decrease in some micronutrients, including Vitamin C.
Perrin is currently collecting and assessing samples from 600 approved milk donors at eight different milk banks from around the world, including the U.S., Kenya, Poland, Chile, and Vietnam, to assess nutrients and bioactive factors and compare samples. The critical work has received $1.4M in funding from the National Institutes of Health.
Her team already has results for over 50 nutrients. Among their preliminary findings, they have discovered donor milk has greater variation in its micronutrients – the vitamins and minerals –compared to its macronutrients – the fat, lactose, and protein.
Perrin and her team plan to use computer modeling to see how milk banks can reduce this variation during the production process. They plan to wrap up and publish this work in the spring.
“This study is important because it is going to establish a very rich reference value for what we can expect the nutrients in donor milk to be. It’s a first step,” Perrin says.
“If we know what’s in donor milk, we can think about how we might change our feeding protocol – such as adding fortifiers to donor milk, to better meet premature infants’ nutritional needs.”
Donated milk is collected by milk banks for processing and distribution. In 2022, Perrin was tapped to be one of 16 members of a World Health Organization group for establishing and implementing safe and quality human milk banking systems. Perrin, the only U.S. researcher, serves as its co-chair.
By creating consistent standards for milk banking, the global group is helping ensure babies most in need of donor milk receive it safely.
“This is a population that didn’t exist 30 years ago – babies that were born around 24 weeks didn’t survive,” Perrin says. “There’s so much work to be done.”
by Rachel Damiani

We understand that too much sedentary activity, especially as we age, is unhealthy. Less well understood is what motivates older adults to be physically active – over the course of the day and within their natural environments.
UNCG Associate Professor of Kinesiology Jaclyn Maher has pioneered methods to find out. We sat down to chat with the internationally recognized early-career scholar, who already has 72 publications and nearly 4,000 citations to her name.
“I’m passionate about being able to generate new knowledge and helping inform physical activity promotion efforts. That’s really powerful, I think. What keeps me coming back to this work is the freedom I have to explore the things that I am passionate about.”
Most researchers in her area study conscious motivations behind physical activity. Maher is seeking to understand how automatic, possibly unconscious, processes influence the physical activity of older adults: how cues in daily life lead one to take a walk, for example, and how people can design cues for themselves to develop physical activity habits. She is trying to help older adults be more active automatically, with less deliberation that requires conscious mental effort.
“Older adults represent one of the least active, most sedentary and fastestgrowing segments of the population, which makes this work particularly impactful. There is a huge need and a lot of room to move the needle.”
“People are living longer, and we want to make sure that those additional years of life are quality years. This also has ripple effects for society by reducing healthcare spending and lessening the burden on caregivers.”
Maher has demonstrated that momentary motivational states within someone’s day predict their physical activity behaviors better than their overall levels of motivation. She was also the first to prove that a tool used by kinesiologists to study youth and adults – called ecological momentary assessment – works with older adults in general and with older adults from vulnerable and understudied populations.
“Using smartphone prompts multiple times per day, we are able to obtain inthe-moment information about people’s physical activity, their motivation to be active, or how the place they are in and the people they are with are influencing their decisions to be active.
“We found that this method is feasible with older adults from a wide range of backgrounds. And also, they are providing valid information in their responses on the smartphone that matches the physical monitors they are wearing.”
Maher, who has been funded by the NIH and American College of Sports Medicine, doesn’t work alone. In eight years at UNCG, she has mentored nine graduate students and more than 50 undergraduate students in her lab.
“The thing that I enjoy most about mentoring is that I meet so many talented students and I get to help them appreciate their full potential and all the things they’re capable of doing. It’s always very impressive to me, when I challenge them to develop a research question or design a study to answer that question, to watch them rise to the challenge. Then I say, ‘Okay, we have the data, now let’s run the analyses and write up the results.’ To see students grow in that process is really rewarding.”
Outside of the lab and classroom, Maher continues to challenge herself physically as well. The former competitive softball player and threetime marathoner has had two
“I started working with a personal trainer at UNCG at the Kaplan Center this past year. One of the things that happens in your thirties is you start losing muscle mass, so I’ve been trying to work on that. My son loves to ride his bike, and we put our daughter in a toddler seat on one of our adult bikes. It is a great way for our family to spend quality time together while also being active.”

by Elizabeth Witherspoon


One of UNCG’s newest institutes will power a growing cluster of research, education, and workforce training initiatives to secure North Carolina’s place as a center for advanced battery and energy technologies.
The BRIGHT Institute will bring together four currents of activity:
A portfolio of next-generation energy research efforts at UNCG along with complementary efforts at other North Carolina universities
North Carolina’s burgeoning private sector “Battery Belt,” anchored by the $14 billion Toyota battery plant set to open this year in the Triad
Extensive local deposits of critical minerals, such as lithium and phosphorus
Surging demand for workers who are educated and trained in the skills needed for electric vehicle battery plants and other innovative employers
BRIGHT, the UNCG Battery Research, Innovation, and next-Gen Energy Harvesting Technologies Institute, will be a hub for more than 100 industry, government, and nonprofit partnerships. It aims to drive innovation and prepare people for careers in this growing industry.
“This will significantly benefit North Carolina economically and socially – pillars of UNCG’s Forward Together 2025-2030 Strategic Plan,” says UNCG Chancellor Franklin D. Gilliam, Jr.

Called the Battery Belt, North Carolina is home to a growing battery-manufacturing presence. Toyota Battery Manufacturing North Carolina is building the company’s first plant to develop and produce lithium-ion automotive batteries just a 30-minute drive from Greensboro. Production is expected to begin this year and eventually employ more than 5,000.
“Toyota Tsusho is committed to investing in the Piedmont Triad region and actively pursuing new opportunities to strengthen the battery value chain across North America,” says Evan Leon, senior project manager for the Battery Project of Toyota Tsusho America, Inc. “We are dedicated to fostering growth and innovation in this vital sector.”
Other big battery-related projects include a Japanese battery-component plant in Davidson County and a battery materials processing plant in Brunswick County.
North Carolina is also home to large lithium ore deposits. The Carolina Tin-Spodumene Belt is a 25-mile-long belt of ore stretching from the northern to the southern state line that has attracted mining and excavation operations. Phosphate is another key mineral for batteries, and North Carolina has the largest integrated phosphate mine in the world.
The state is attracting and growing its own companies along the entire electric vehicle – EV – supply chain: from lithium mining and extracting, to battery innovation and the automotive industry, to design and manufacturing of charging stations, and points in between. Add to that pioneering research at UNCG and other universities and an available workforce, and North Carolina is full of potential to become an international driver for this strategic sector of the economy.
“We can leverage the strengths at UNCG in a variety of fields that align with the needs of our region and industry partners,” says Vice Chancellor for Research and Engagement Sherine Obare. “We have expertise and partnerships intersecting with the economics of the energy transition, urban growth dynamics related to electric vehicle infrastructure, biological sources for new energy solutions, and more.”
North Carolina has rich deposits of critical minerals that form the foundation for next-generation battery and electrification technologies. BRIGHT’s cutting-edge research in material recovery, safe and sustainable extraction, and advanced processing technologies buttresses national security and economic resilience – building a more secure, sustainable future.

“North Carolina has an opportunity to become a world leader in electrification and battery technologies,” says Dr. Hemali Rathnayake, a professor of nanoscience at UNCG who will lead the BRIGHT Institute. Rathnayake’s own research, which focuses on organic and polymeric materials, has led to a spin-off company concentrating on harvesting lithium sustainably.

As a leader and convener, BRIGHT focuses on three areas:
The institute launched in March 2025 with a Critical Materials Symposium that gathered experts from each of these sectors to discuss challenges and opportunities. Topics included critical materials supply chains, battery technology innovations, workforce development, policy issues, and more.
These conversations provided traction for immediate progress in each of the Institute’s core areas. Oak Ridge National Laboratory, the federally funded research center at the forefront of supercomputing, advanced manufacturing, materials and energy research, and more, agreed to partner with BRIGHT on research. Mass Tech Consultant Group to Tata Battery Industries plans to send 10 employees to the institute as the first cohort of a 7-week industry-focused, hands-on training program. Mass Tech is also funding the first BRIGHT Institute graduate student fellowship in battery development and manufacturing, with plans for more industry-sponsored graduate fellowships in the works.
Meanwhile, over the summer, a first group of graduate students underwent hands-on battery training through the institute. Beginning in fall 2025, upper-level undergraduates and graduate students can enroll in the same UNCG training to prepare them for battery industry careers.
Students interested in other aspects of the battery industry can also enroll in a new offering from the UNCG Bryan School of Business & Economics. “The Graduate Certificate in Strategic Procurement and Supply Chain Management curriculum applies to the battery industry as well as many other industries,” says lecturer Samuel Chinnis, who directs the Department of Information Systems and Supply Chain Management certificate.
UNCG nanoscience researchers are seeking to improve lithium extraction processes and build better cathodes. Other faculty analyze the economics of electric vehicle adoption, its effect on urban growth patterns, and the environmental effects of different types of electric power generation to recharge EVs. And there’s more. The BRIGHT Institute’s research portfolio will shed light on a wide range of basic and applied science critical to the growing electrification of our economy.
Applied science research led Rathnayake and her former student, Dr. Sheeba Dawood, to spin out their company Minerva Lithium to develop a patented filter technology that recovers lithium from water resources.
“The company aims to advance this patented filter technology, which recovers lithium from other lithium-rich resources, like from the Spodumene Belt in North Carolina,” Rathnayake says.
She and her team also acquired U.S. Department of Defense HBCU/MI Equipment program funding for of a state-of-the-art 3D super-resolution microscope for imaging of live cells. The $800,000 ZEISS Elyra 7 enables the real-time study of structural features in biological systems as small as 60 nanometers – less than the width of a human hair.
This high resolution enables researchers at BRIGHT to study the interactions between nano materials and microorganisms. Insights into how nature functions could lead to new ways to build batteries and electronics based on biological structures and processes.
Dr. Robson Grosso, a nanoscientist with industry experience, is senior scientist at BRIGHT and runs Rathnayake’s lab. He also builds battery cathodes, conducts research, and trains other researchers, including students.
Grosso is working to improve the fundamental properties of batteries, finding ways to design them so they’ll last longer and be safer and more stable. Better batteries are also likely to accelerate EV adoption, he says.



“We have so many companies, but we don’t yet have enough people with battery expertise here,” says Grosso.
“The institute is needed.”

Dr. Selima Sultana, professor and associate head of the Department of Geography, Environment, and Sustainability, examines the role of EV technologies from the perspective of an urban and transportation researcher.
“Urban and transport planners will need to focus on issues such as accessibility of public EV chargers, current obstacles and prospects in deploying public EV charging infrastructure, and the needs and preferences for public EV chargers in different locations,” she says. “In addition, they must consider equity and fairness issues associated with public EV charging infrastructure.”
Sultana says planners will need to forecast mass-scale EV adoption and its impact on urban growth and planning. For example, how much parking will be needed around charging infrastructure?
And she anticipates needing to understand how widespread EV adoption will influence travel behavior and the overall transportation system. Could traffic patterns and congestion levels change as more people drive electric vehicles, choose different routes, or make different choices about using public transit?
Meanwhile, Dr. Stephen Holland, a professor of economics, analyzes carbon dioxide emissions of EVs. EVs don’t directly emit CO2 from tailpipes like gasolinepowered vehicles do. However, they can indirectly contribute to overall CO2 emissions if fossil fuels are used to generate electricity for recharging their batteries.
In the past, when 70 percent of U.S. electrical power was generated by burning coal or natural gas, Holland found there weren’t short-term benefits from using EVs.
But as new forms of power generation, such as solar and wind, have come online in California, for example, and more people have bought EVs, he’s found lower levels of CO2 emissions from EV use compared to gaspowered vehicles.
Holland is also examining the economics of electrical energy storage for industry, such as large data centers that may generate some or all of their electricity from nearby wind or solar sources.
The diverse but relevant range of expertise at UNCG – in technological innovation, social sciences, business and social innovation, and workforce development and social mobility – is what sparked the idea for the institute for UNCG’s new vice chancellor for research and engagement.
“We are well-positioned to do this transformative work,” says Obare.
by Elizabeth Witherspoon
Biochar, a centuries-old technology for enriching depleted agricultural soils, has been getting a second look in recent years as a solution to new challenges: making fire-resistant building materials, storing carbon from the atmosphere, and at UNCG, removing toxins from water. Dr. Jianjun Wei is researching ways to optimize biochar to remove lead, mercury, and other heavy metals, plus emergent chemicals known as PFAS, from water.
“Biochar” is a porous charcoal made from carbon-based materials, or biomass. It’s made by burning organic waste – such as sawdust, agricultural residues, and manure – in low-oxygen environments.
The Forest Service’s Forest Products Laboratory has been working over a decade to develop processes that produce biochar with different characteristics, the nanoscience professor and chemist says. They see biochar as a valuable use for massive woody residues left in forests after harvesting, wildfires, and insect and disease outbreaks. With USDA funding, Wei and doctoral student Sherif Bukari are exploring how Forest Service biochar can best clean contaminated water.
Wei has a long history of carbon materials work. His research focuses on nanomaterials – ones so tiny they’re invisible to the unaided eye and hard to detect with conventional microscopy. Recently, he’s been studying ways to use such materials in environmental remediation. For example, he has explored ways to clean antibiotic-resistant bacteria from water and detect toxic organophosphates from pesticides.
Wei’s team alters the biochar so it binds better to toxic pollutants – specifically, heavy metals ions and chemicals known as PFAS.
Per- and polyfluoroalkyl substances, dubbed “forever chemicals” since they don’t break down in the human body or the environment, have been used in many products since the 1940s – including cosmetics, non-stick cookware, food packaging, and firefighting foams.
Recent studies have linked even low PFAS exposures to serious health effects. It’s long been known that heavy metals can be toxic, causing liver and kidney damage, cognitive impairment, cancer, and other ailments.
Heavy metal ions and PFAS are in very stable complexes and don’t biodegrade easily, making them tough to remove from water.

“TRAINING EMERGING SCIENTISTS is a top priority in my research.” Since leaving industry work for UNCG in 2013, Wei has mentored 26 doctoral students and four postdocs.
“Biochar is highly porous and has a large surface area, so there are many advantages to using it in the environment to remove contaminants,” Wei says. “But if we don’t modify the biochar, it doesn’t bind well to our targets.”
Wei’s team is working to increase that affinity, first by studying how heavy metal ions and PFAS interact with biochar with different surface modifications.
While other researchers have focused on powdered biochar, Wei reports biochar-based panels have advantages. Water would pass through the panels, leaving heavy metal ions or PFAS clinging to the surface. Once saturated, panels can be treated to remove contaminants and then reused, he says.
Wei is committed to using nanoscience to make the world better – particularly environmental quality. He points to statistics showing many U.S. water bodies are considered impaired and below EPA standards. These types of problems exist worldwide.
“We are hoping to commercialize this research, so that in the end, it has a big impact,” he says.
Wei’s work has been funded by the NSF, Department of Energy, NIH, NC Biotechnology Center, Department of Defense, and Syngenta, LLC.
by Dee Shore, AMBCopy LLC
Excitement was high when UNCG’s Spartan Cyber Guardian Academy opened in January 2025 with a $1 million grant from Google. Since then, the numbers of students seeking cybersecurity training, and organizations seeking their services, have already exceeded clinic leaders’ expectations.
UNCG’s Google-funded cybersecurity clinic is the first at a North Carolina university.
With funding and wraparound support from Google, the academy uses a service-learning clinic model to provide free, hands-on experience in industry-standard cybersecurity frameworks and auditing. Clinic clients are regional organizations, such as small businesses and nonprofit organizations, that lack resources for comprehensive cybersecurity threat analysis and protection.
The academy aims to strengthen the region’s cybersecurity landscape while training the next generation of cybersecurity professionals.
“The goal we set with Google was to serve 16 clients total during the 2025 spring and fall semesters,” said clinic director Dr. Moez Farokhnia Hamedani, an assistant professor of information systems and supply chain management in the Bryan School of Business and Economics. “But we received many more applications from organizations and served 13 nonprofits in the spring alone.”
Likewise, from the 60 students who applied to participate in spring 2025, the academy trained 46, surpassing its goal of 40. The students work in 3- to 5-member teams with a faculty mentor or industry professional to audit an organization’s cybersecurity status and level of readiness. Then, they make actionable recommendations on how to reduce the organization’s vulnerability and better protect it against potential threats.
In two cases, Farokhnia Hamedani says, organizations have been so impressed, they interviewed students for part-time paid internships to implement the recommendations. Several students had such good experiences that they asked for the opportunity to participate again.
In addition to gaining invaluable experience with real-world clients, students receive comprehensive cybersecurity training, including MIT’s Cybersecurity for Critical Urban Infrastructure course, Google Cybersecurity Certification, and a series of customized training sessions for cybersecurity assessments based
on the National Institute for Standards and Technology’s National Initiative for Cybersecurity Education Framework.
Students also have the opportunity to connect with other trainees and trainers within the Consortium of Cybersecurity Clinics, which includes 39 academic and industry institutions.
Upon completion of the clinic project, students are eligible to receive a voucher for the Security+ certification exam or comparable certifications, such as Network+, which cost $404 and $358, respectively. The opportunity to earn industry-recognized certifications significantly enhances their employability.
Dr. Lakshmi Iyer, professor of information systems and supply chain management and department head, believes the keen interest is driven by need and the academy leadership team’s work to build trust. She, along with Farokhnia Hamedani and associate professor A.F. Salam, are co-principal investigators for the Google grant. Iyer and Farokhnia Hamedani have previously published research on how employee turnover can increase the risk of data breaches. Now, they will collect evaluation data from cybersecurity clinic students and clients to add to their growing body of cybersecurity research and improve the program in real time.
“Nonprofits and small and medium businesses are the primary focus of this service because they lack staff resources and expertise to address heightened cybersecurity concerns as they concentrate on their core missions,” Iyer says. “Yet, these small organizations are among the most vulnerable should they lose membership or donor lists to a security breach.”
174 nonprofits & businesses supported by Elizabeth Witherspoon
870+ individuals trained



with community health care organizations including Cone Health, have provided evidence-based services to over 2,000 patients thus far in their efforts to bring remarkable, real-world impact to our region.